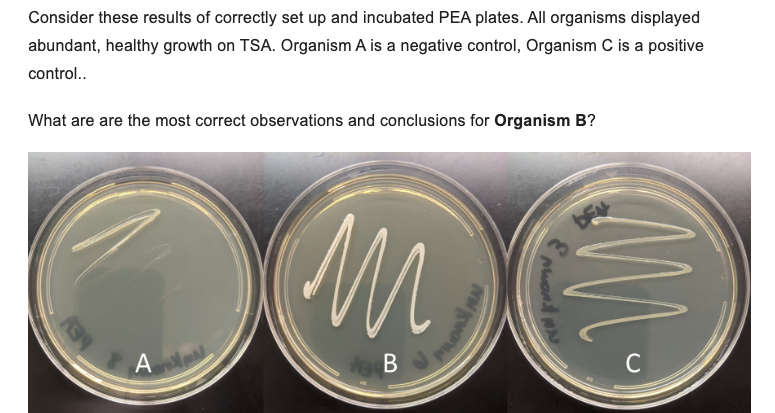

Home /
Expert Answers /
Biology /
consider-these-results-of-correctly-set-up-and-incubated-pea-plates-all-organisms-displayed-abund-pa127
(Solved): Consider these results of correctly set up and incubated PEA plates. All organisms displayed abund ...
Consider these results of correctly set up and incubated PEA plates. All organisms displayed abundant, healthy growth on TSA. Organism is a negative control, Organism is a positive control.. What are are the most correct observations and conclusions for Organism B?
Expert Answer
Ans:for organisms BMany bacteriologists have tried, with var